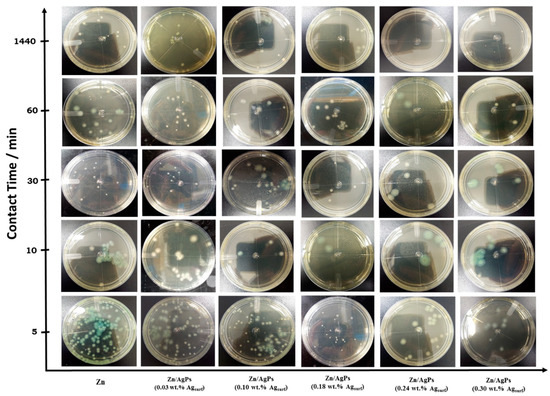

Abstract
In this work, zinc/silver particle (Zn/AgP) composite coatings were manufactured by electrodeposition to investigate their antibacterial capacity and corrosion rate in physiological environments. The morphology and composition of the coatings were analysed by glow-discharge optical emission spectroscopy and scanning electron microscopy coupled to an energy dispersive spectrometer. The results showed the formation of Zn/AgP composite coatings with a homogeneous distribution of Ag throughout the coating surface and depth. Additionally, the Ag content in the coatings increased with increasing concentrations of AgP in the electrolytic solution. The Zn/AgP composite coatings with 0.30 wt.% Ag on the surface (0.30 wt.% Agsurf) showed efficiencies close to 100% growth inhibition of the bacteria Pseudomonas aeruginosa after 10 min of contact. The corrosion rate of the Zn and the Zn/AgP (0.30 wt.% Agsurf) coatings in Hank’s, Ringer’s and Phosphate buffered saline (PBS) solutions was evaluated by polarization curves and by immersion tests over different time periods (7, 30, and 40 days). The corrosion rate of the Zn/AgP (0.30 wt.% Agsurf) coatings was on the order of tenths of microns per year and the amount of zinc mass dissolving per day was in the range of 0.15 to 0.7 mg cm−2. Additionally, the surface of the coatings was analysed by X-ray diffraction (XRD) after 40 days of immersion. These results showed the formation of ZnO, as the main corrosion product, in the samples immersed in Hank’s and Ringer’s solutions. In the samples immersed in PBS, the formation of a passivating film of Zn2(PO4)3·2H2O was detected.
1. Introduction
A current trend in the technological development of materials is the use of biodegradable metals, which have been proposed as an alternative in the manufacturing of temporary implants, that is, in implants that should only be used during the time necessary to heal the wound; these metals must subsequently be degraded and bioabsorbed completely to be discarded by the body. Metals such as Fe, Mn, Mg, Zn, and W have been proposed as biodegradable metals [1], with Mg being the most accepted due to its physical characteristics and biocompatibility. Mg has a density of 1.74 g cm−3, which is very similar to that of human cortical bone (1.75 g cm−3), and its Young’s modulus (41 to 45 GPa) is also close to that of human bone (3 to 20 GPs). Additionally, Mg participates in many metabolic reactions and is a metal that is present in large amounts in the human body; the daily demand for magnesium is 375 mg [2]. Due to these characteristics, Mg is an ideal candidate as a biodegradable material for temporary implants, such as cardiovascular stents. Despite the advantages of Mg as a biodegradable implant, its use has been restricted due to its high corrosion rate (250 μm yr−1) in the physiological environment with high concentrations of chloride ions, which cause Mg-based implants to degrade before achieving complete healing [3]. Additionally, the Mg oxidation process produces hydrogen bubbles, and this production slows the healing process.
Several materials have been studied as Mg substitutes for use in biodegradable implants [2]; these materials have been the main basis for the development of various types of alloys. In this regard, Heublein et al. [4] tested the magnesium alloy AE21 as a coronary stent, observing a rapid degradation of the alloy over a period of 35 to 56 days after implantation. On the other hand, Krause et al. [5] tested the Mg-0.8Ca alloy in vivo, finding that it was very stable because it maintained more than half its volume after implantation in the tibia of rabbit. Mg-6Zn binary alloys were studied by Zhang et al. [6], finding good in vitro biocompatibility and adequate mechanical properties. However, in vivo tests showed that the degradation rate of the alloy was greater than that of Mg. Ternary Mg-Zn-Ca alloys (4 wt.% Zn) have been tested, showing excellent mechanical properties and greater resistance to corrosion [7]. However, after 30 days of exposure in simulated body fluid (SBF) solution, their physical properties decreased considerably.
The utility of Fe as a biodegradable material for implants has been proven in different studies [8,9] without finding toxicity problems, inflammations or restenosis. However, its moderate degradation rate limits its biodegradability and therefore its applications as a biodegradable metal. To overcome this limitation, Fe alloys have also been tested as materials for biodegradable implants. Mantovani et al. [10] investigated the degradation of Fe-Mn alloys under flow conditions, simulating those of a coronary artery, obtaining iron hydroxides and calcium/phosphorus layers as degradation products. On the other hand, Schinhammer et al. [11] demonstrated that the degradation rate of the Fe-Mn-C-(-Pd) alloy is greater than that of the Fe-Mn alloy. The main problem in the use of Fe-Mn alloys is the high content of Mn, which ranges from 20% to 35%, which could cause toxicity problems.
In recent years, zinc [12] and zinc-based alloys have been proposed as alternatives to replace Mg-based alloys because their corrosion rate (~20 μm·yr−1) is lower than that of Mg [13] and because they have high biocompatibility; Zn is one of the most abundant essential nutritional elements in the human body, and the recommended daily requirement of zinc is between 15 and 100 mg day−1 [14]. Additionally, Zn is very important in several biological processes, such as in hormonal mediation and DNA and RNA synthesis; it also participates in nearly 300 enzymatic reactions [15]. In this sense, Niu et al. [16] proposed a Zn-Cu alloy as a biodegradable material for application in vascular stents. Törne et al. [17] studied the degradation mechanism of Zn-Mg and Zn-Ag alloys obtained by smelting at 550 °C, immersed in Ringer’s solutions. The microgalvanic corrosion of the Zn-Ag alloy causes the accumulation of the AgZn3 phase on the surface, and this accumulation could cause complications in the regeneration of the tissue. The Zn-Mg alloy selectively dissolves, causing local precipitation of the corrosion products, which increase the corrosion rate. Similarly, Sikora-Jasinska et al. [18] manufactured Zn-Ag alloys of different compositions by casting at 650 °C, observing an increase in the corrosion rate when increasing the Ag content in the alloy using Hank’s solution as electrolyte. This fact is associated with the greater formation of AgZn3. Additionally, Mostaed et al. [19] studied the corrosion of Zn-Mg alloys formed by hot extrusion in modified Hank’s solution, observing a loss in the mechanical integrity of the alloy due to the increase of the volume fraction of a second phase during the corrosion process, causing local galvanic corrosion pitting. Recently, Hehrlein et al. [20] reported results of in vivo tests using Zn-Ag alloy (3 wt.% Ag) (obtained by smelting at 650 °C) as bioresorbable vascular stents. Their results showed that the degradation of Zn-3Ag stents in porcine iliac arteries occurred without toxicological problems or vascular occlusion and maintained vascular scaffolding for a minimum period of 6 months.
Another option that has been proposed to produce implants with controlled degradation and prolonged mechanical stability is coatings. The coatings are thin films that isolate and protect the substrate from the surrounding environment, maintaining the physical properties of the substrate. One of the main characteristics of the coatings is that they must degrade at a controlled rate so that they will protect the substrate only for a certain time. Various types of biodegradable coatings have been proposed, either organic, such as polylactic acid (PLA) [21], polycaprolactone (PCL) [22] and polypyrrole [23] or inorganics such as calcium phosphates [24] and fluoride [25].
On the other hand, nosocomial infections are one of the most common complications associated with surgical implants. These infections not only cost a large amount of money but also delay the healing time and can even lead to disability and death. It has been shown that bacterial infection is the second most important factor leading to failure in implantation [26]. Therefore, it is important to develop materials with bactericidal capacity that can prevent early infection in the area of the implant.
In this study, we analyzed zinc/silver particle (Zn/AgP) composite coatings as protective biodegradable coatings with antibacterial capacity for potential use in biomedical applications. The Zn/AgP composite coatings were obtained by electrodeposition on American Iron and Steel Institute (AISI) 1018 steel substrates. The bactericidal capacity was evaluated with respect to the bacterium Pseudomonas aeruginosa, as this is one of the main bacteria causing nosocomial infections [27,28]. Corrosion of the coatings in different physiological environments—Ringer’s, Hank’s and PBS solutions—was studied by polarization curves and immersion. The corrosion products were characterized by X-ray diffraction (XRD).
2. Materials and Methods
2.1. Electrodeposition of Zinc/Silver Particle (Zn/AgP) Composites Coatings
The Zn/AgP composite coatings were formed by galvanostatic electrodeposition, applying a current density of 8.5 mA cm−2 for 60 min at 25 °C, using a S0 solution (= 81 g·L−1 ZnCl2 + 25 g·L−1 H3BO3, + 208.8 g·L−1 KCl + 1.5 g·L−1 PEG 8000 + 0.2 g·L−1 BDA + 0.03 g·L−1 cetyl trimethylammonium hydrogen sulphate (CTHS) + 2.8 g·L−1 triethanolamine) + x g·L−1 AgPs (x = 0, 0.5, 1.5, 2.5, 3.5 or 4.5). The average size of the silver particles (AgPs) was 60 nm (99.9%, SkySpring Nanomaterials Inc., Houston, TX, USA), the size of the silver particles was selected from additional bacteriological tests (not presented in this work), using silver particles of different sizes: 30, 60, and 100 nm. Each solution was prepared before each experiment using analytical-grade reagents (99.9% purity, Sigma Aldrich, St. Louis, MI, USA). A parallel plate cell manufactured in acrylic with a distance of 5 cm between electrodes was used as the electrochemical cell. As a cathode, AISI 1018 steel plates (8 cm2 of exposed area) were used and were previously degreased and activated. Zn plates (99%, Atotech, Feucht, Germany) were used as anodes.
2.2. Chemical Composition and Morphological Characterization
The elemental composition profiles as a function of the thickness of the Zn/AgP composite coatings were obtained using glow-discharge optical emission spectrometry (GD-OES) (Profilometer 2, Horiba, Kyoto, Japan), setting the following parameters: 650 Pa and 35 W. The following spectral lines were recorded: 130.21 nm O, 481.05 nm Zn, 328.06 nm Ag, 156.14 nm C, 385.99 nm Fe, 121.56 nm H, and 149.26 nm N. The morphology and surface composition of the coatings was analyzed by scanning electron microscopy (JEOL JSM-6510 LV, Tokyo, Japan) coupled to an energy-dispersive X-ray spectroscope (SEM-EDX) (Bruker Quantax 200, Berlin, Germany), with an acceleration voltage of 55 kV, using SE imaging. Atomic Force Microscopy (AFM) (Asylum Research, Mod. MFP-3D, Santa Barbara, CA, USA) in tapping mode was used to obtain images of the Zn/AgP composite coatings. All images were obtained at 1.5 Hz.
2.3. Antibacterial Activity of the Zn/AgP Composite Coatings
The antibacterial activity of the Zn/AgP composite coatings was analyzed with respect to Pseudomonas aeruginosa (P. aeruginosa) NEJ01R according to International Standarization Organization (ISO) method 22196, “Measurement of antibacterial activity on plastics and other non-porous surfaces” [29]. This strain was inoculated in Luria Bertani broth (LB) (bacto-tryptone, 10 g; yeast extract, 5 g; NaCl, 10 g and deionized water, up to 1000 mL) and incubated for 24 h at 30 °C and 150 rpm. After reaching a cell density of 109 CFU mL−1 (CFU: colony forming unit), evaluated from turbidity measurements (15% transmittance, 650 nm), the Zn/AgP composites with different Ag content were placed in the fermentation broth and maintained for contact times of 0.0, 5, 10, 30, 60 and 1440 min. After this time, cell density was diluted to 108 CFU mL−1 in 0.1 mM phosphate buffer pH 7.0. Petri dishes with LB agar were inoculated with 1 mL of the 108 CFU mL−1 dilution and incubated at 30 °C for 24 h. After the incubation period, the CFU mL−1 was determined by counting the number of colonies established on the agar plate using a colony counter (Mod. Galaxy 230, Rocher Scientific, Taipei, Taiwan). As a control, a Zn coating without AgP was used. The quantification was realized as in ASTM E2149-01, “Standard test method for determining the antimicrobial activity of immobilized antimicrobial agents under dynamic contact conditions” [30]. The percentage reduction of the organisms resulting after different contact times (5, 10, 30, 60, and 1440 min.) between the Zn/AgP composite coatings and the bacterial strain was calculated using reduction percentage (%) = ((B−A)/B) × 100, where A = CFU per milliliter in the flask containing the treated substrate after the different contact times, B = the number of initial CFU mL−1 before the addition of the treated substrate.
2.4. Corrosion Test
Corrosion tests for polarization curves were performed according to the ASTM G59-97 standard [31] using a conventional three-electrode cell and a Bio-logic SP150 potentiostat/galvanostat. A saturated calomel electrode (SCE) was used as the reference electrode, and a platinum mesh was used as the counter electrode, each placed inside a separate compartment. For this study, Zn or Zn/AgP composite (0.30 wt.% Agsurf) coatings were prepared on electrodes made of AISI 1018 steel with an exposed geometric area of 1.5 cm2.
The corrosion behavior of the Zn/AgP coatings was studied in different solutions: Hank’s, Ringer´s and PBS (Sigma Aldrich, St. Louis, MI, USA), whose compositions, reported by the manufacturer, are shown in Table 1:

Table 1.
Composition of the physiological solutions used in the corrosion tests.
2.5. Immersion Test
The immersion corrosion tests were performed according to the NACE TMO 169/G31-12a standard [32]. Rectangular plates of AISI 1018 steel coated on both sides with Zn or Zn/AgP composite (0.30 wt.% Agsurf) were immersed in sterilized glass containers with 200 mL of saline solution (Hank’s, Ringer’s or PBS). The immersed area of each sample was 8 cm2 (1.0 cm × 4 cm per face). The temperature was maintained at 37 °C with a recirculating bath, pH = 7.0. The samples of Zn and Zn/AgP (0.30 wt.% Agsurf) immersed in each of the solutions were removed and analyzed after different test times: 7, 22, and 40 days. After the immersion corrosion tests, the surface morphology was analyzed by SEM-EDX, and the formed phases were analyzed by XRD using a Bruker diffractometer (model D8 Advance) in Bragg–Brentano configuration, with a Cu Kα radiation source (λ = 1.54 Å) and scanning from 30° to 150° of 2θ° with a scan rate of 0.2° s−1.
3. Results
3.1. Chemical Composition and Morphology of Zn/AgP Composite Coatings
The influence of the concentration of silver particles (AgP) in the electrolytic solution on the morphology and elemental composition of the Zn/AgP composite coatings was studied by forming Zn/AgP composite coatings on AISI 1018 steel plates using S0 solutions with different concentrations of AgP (S0 + x g·L−1 AgP (x = 0, 0.5, 1.5, 2.5, 3.5 and 4.5)). The Zn/AgP composite coatings were formed by applying a current density of 8.5 mA·cm−2 for 60 min at 25 °C. The morphological characteristics of the coatings were analyzed by SEM-EDX and AFM and are shown in Figure 1. The SEM images show that the morphology of the coatings depends on the concentration of AgP in the solution. In the absence of AgP (solution S0) (Figure 1a) the obtained coatings were compact, smooth, with a roughness factor, Ra, of 0.65 mm; some micropores are observed on the surface (see inset of Figure 1a), due to the simultaneous formation of H2 bubbles by the simultaneous reduction of water during zinc deposition. By increasing the concentration of AgP in the electrolytic solution in the range of 0.5 to 2.5 g·L−1 (Figure 1b–d), the Zn/AgP composite coatings that forms are more compact and formed of semi-spherical clusters (see insets of Figure 1b–d), with a significant decrease in the number of pores. This result is attributed to the partial inhibition of H2 evolution by the blocking effect of some active sites by the adsorption of AgP; in addition, the roughness of the coatings increased from 0.69 to 0.81 µm, respectively. An important change in the morphology of the coatings was observed when the coatings were obtained from electrolytic solutions with concentrations of AgP greater than 2.5 g·L−1. Zn/AgP composite coatings obtained from electrolytic solutions with AgP concentrations between 3.5 and 4.5 g·L−1 (Figure 1e,f) were smooth, with crystals oriented perpendicularly to the substrate surface, resulting in the formation of a needle-like surface morphology (see Figure S1, additional information). This morphology was similar to that obtained when polyethoxylated compounds were used as surfactant additives, e.g., PEG 8000 [33] and PEG 20,000 [34,35], for the formation of metal electrodeposits, this result confirms the action of the AgP on the substrate surface. The roughness measured in these coatings was 0.84 and 1.12 µm, respectively.

Figure 1.
SEM and AFM (insets) images of Zn/AgP composite coatings obtained from different electrolytes: (a) S0 (= 81 g·L−1 ZnCl2 + 25 g·L−1 H3BO3, + 208.8 g·L−1 KCl + 1.5 g·L−1 PEG 8000 + 0.2 g·L−1 BDA + 0.03 g·L−1 cetyl trimethylammonium hydrogen sulphate (CTHS) + 2.8 g·L−1 triethanolamine), (b) S0 + 0.5 g·L−1 AgP, (c) S0 + 1.5 g·L−1 AgP, (d) S0 + g·L−1 AgP, (e) S0 + 3.5 g·L−1 AgP, (f) S0 + 4.5 g·L−1 AgP.
The elemental mapping analysis obtained from the surface of the Zn/AgP composite coatings presented in Figure 1d is shown in Figure 2. The EDX surface analysis of the coating detected the presence of Zn, O and Ag homogenously distributed on the surface. This detection confirmed the formation of the Zn/AgP composite coating, as well as the surface oxides associated with the reaction of the coating with the air. Similar results were obtained for all coatings (Figure S2, additional information).

Figure 2.
Elemental mapping analyses of the Zn/AgP coatings shown in Figure 1d.
Table 2 shows the results obtained by EDX of the content of Ag on the surface (wt.% Agsurf) of the Zn/AgP coatings formed from solutions with different concentrations of AgP. The surface Ag content (wt.% Agsurf) increased with the concentration of AgP in the electrolytic solution, reaching a maximum of 0.30 wt.% Ag (0.30 wt.% Agsurf) when the concentration of AgP in the solution was equal to 4.5 g·L−1. In previous studies, we have shown that the occlusion and homogeneous distribution of an inert particle in metal/inert particle composite coatings is favoured by the use of cationic dispersants [36] (e.g., cetyl trimethylammonium hydrogen sulphate (CTHS), used in this work). This effect is associated with the positive surface charge of the surfactant, which, in addition to stabilizing the particles in the colloidal suspension, promotes their migration towards the surface of the cathode (negatively charged electrode).

Table 2.
Results obtained by EDX of the content of Ag on the surface (wt.% Agsurf) of the Zn/AgP coatings formed from solutions with different concentrations of AgP.
GD-OES analysis was performed to obtain information on the composition and distribution of the elements through the thickness of the Zn/AgP composite coatings formed under different conditions. Figure 3 shows the typical profile of the distribution of the elements as a function of the thickness of a Zn/AgP composite coating. For clarity, the H and Ag signals were multiplied by 250. Four regions can be observed in the figure. In the first region, in the depth range from 0 to 0.5 µm, which corresponds to the surface of the coating, the presence of O and Zn is observed. The presence of oxygen on the surface of the coating is indicative of the formation of a surface oxide film. Additionally, a high percentage of Ag is observed and can be associated mainly with an excess of Ag that adhered to the surface after the electrodeposition process and that was not eliminated during the subsequent rinse. After removing the surface oxide film, the second region is observed in the depth range of 0.5 to 7.5 µm, corresponding to the Zn/AgP composite coating. In this region, Zn (~99%), Ag (~0.03%) and H (~0.02%) signals are observed and exhibit a similar and constant behaviour throughout the region; this outcome is indicative of a uniform distribution of these elements throughout the thickness of the coating, as well as the simultaneous co-deposition of Zn and AgP to form the Zn/AgP composite coatings. Subsequently, in the approximate range of 7.5 to 11.5 µm (third region), the growth of the Fe signal (substrate) is observed, as well as the simultaneous decrease of the Zn and Ag signals, indicative of the formation of an interface between the substrate and the coating. At depths greater than 11.5 µm (fourth region), there is a constant signal of the Fe substrate (~100%), indicating that the substrate has been reached. A similar behaviour, but with different signal intensities, was observed for all of the obtained coatings (Figure S3 additional information). Unlike the EDX results, which show only the surface presence of the elements and not their distribution inside the coatings, the results obtained by GD-OES confirm the homogeneous occlusion of AgP throughout the thickness of the coatings and complement the results obtained by EDX.

Figure 3.
Typical GD-OES profile obtained from a Zn/AgP composite coating formed by applying 8.5 mA cm−2 for 60 min a 25 °C.
3.2. Antibacterial Activity of the Zn/AgP Composite Coatings
One of the potential applications of Zn/AgP composite coatings is their use as a protective coating of implants or prostheses, which is why it is important to evaluate their bactericidal activity with respect to bacteria that cause internal infections. Nosocomial and post-operative infections caused by the Gram-negative bacteria P. aeruginosa are recognized as an acute problem in hospitals due to their intrinsic resistance to many antibiotics [28,37,38]. In this work, the antibacterial activity of the Zn/AgP composite coatings with different AgP contents, occluded in their metal matrix, was evaluated against P. aeruginosa bacteria during different contact times: 5, 10, 30, 60, and 1440 min, following the methodology described in Section 2.3. The results obtained (Figure 4) show that by increasing the content of Ag in the Zn/AgP composite coatings and the contact time, the bacterial growth decreases considerably.
Figure 4.
Agar plate assays to assess the antibacterial activity of Zn/AgP composite coatings with different contents (wt.%) of Ag and different contact times with the pathogenic Gram-negative bacterial strain P. aeruginosa and 24 h de incubation.
In Table 3, the results concerning the cell density in CFU mL−1 units evaluated in each Petri dish, are shown. Results show that by increasing the contact time and the Ag content in the coatings, the cell density decreases. According to these results, the greatest bacterial growth inhibitory effect is observed for AgP concentrations in the coatings greater than or equal to 0.18 wt.% Ag and contact times equal to or greater than 30 min.

Table 3.
Final bacterial (P. aeruginosa) concentrations after different contact times between the fermentation broth and Zn/AgP surfaces with different AgP concentrations in the coatings and 24 h de incubation.
The percentage of inhibition of bacterial growth was calculated by quantifying the change in cell density, number of CFU mL−1, with respect to the number of initial CFU mL−1 present in 10 mL of a cell suspension after different contact times (5, 10, 30, 60, and 1440 min.) between the Zn/AgP composite coatings and the cell suspension (see Table 3). Each test was performed in triplicate, and the reported result is the average value of these measurements. Figure 5 show that a coating of pure Zn inhibits the bacterial growth of P. aeruginosa up to 36.6% ± 5.1% after 1440 min of contact, which confirms the previously reported antibacterial capacity of pure Zn [39]. Likewise, for the Zn/AgP composite coatings with Ag content in the range of 0.18 wt.% to 0.30 wt.% Agsurf, percentages of inhibition greater than 90% were observed after 30 min of contact, until reaching values close to 100% inhibition after 60 min of contact time. The highest percentage of inhibition is observed for Zn/AgP with 0.30 wt.% Agsurf. Therefore, the Zn/AgP composite coatings are highly efficient as antibacterial coatings that can inhibit the growth of bacteria that cause serious internal infections.

Figure 5.
Percentage of inhibition of P. aeruginosa, obtained from counting viable cells in the Petri dish shown in Figure 4.
3.3. Corrosion Tests
3.3.1. Polarization Curves
To evaluate the corrosion rate of coatings in different physiological environments, polarization curves were obtained for the Zn/AgP (0.30 wt.% Agsurf) composite coatings and the Zn coating (this coating as reference) immersed in solutions that simulate a physiological environment. The physiological environments selected, Hank’s solution [16,40], Ringer’s solution [41] and phosphate-buffered saline (PBS) [12], are the most commonly used electrolytic models for in vitro biodegradability studies. The corrosion current density (jcorr) and the corrosion potential (Ecorr) were obtained graphically using the Tafel extrapolation method. The corrosion rate was calculated using the following equation [31]:
where CR is the corrosion rate (mm yr−1), jcorr is the corrosion current density (µA cm−2), EW is the equivalent weight of Zn (EW = 32.5), and ρ is the density of Zn (7.13 g cm−3). Due to the low percentage of Ag in the Zn/AgP (0.30 wt.% Agsurf) composite coatings, we considered the coating to be pure Zn for these calculations. The tests were performed in triplicate for each coating in each solution, and the results reported correspond to the average value obtained. Testing was performed 50 min after immersion in the range of potential −1.350 to 0.0 V vs. SCE and with a potential sweep rate of 0.167 mV s−1. Figure 6 shows the polarization curves obtained for the Zn coatings (Figure 6a) and for the Zn/AgP (0.30 wt.% Agsurf) composite coatings (Figure 6b) in the different physiological solutions. In both coatings, the corrosion potential and the corrosion current density depended on the electrolyte. Additionally, the polarization curves obtained for both coatings in PBS showed passivating characteristics in the region anodic, obtaining passivating current values of 389.20 µA cm−2 for the Zn coating and 70.80 µA cm−2 for the Zn/AgP composite coating. This behaviour was associated with the formation of a passivating film, possibly composed of phosphates, oxides and zinc hydroxides adhered to the surface of the electrode. The formation of this film is possible because during the dissolution of the coating, the Zn2+ ions and PO42− ions present in the PBS electrolyte can react to form insoluble zinc phosphate compounds, which have dielectric properties, on the surface of the electrode.

Figure 6.
Polarization curves obtained from (a) Zn coatings and (b) Zn/AgPs (0.30 wt.% Agsurf) in different physiological solutions.
Table 4 shows the values of Ecorr, Jcorr and CR obtained from the polarization curves. The highest value of Ecorr was obtained for the Zn and Zn/AgP composite coatings immersed in PBS, and this behaviour was similar to that reported by Törne et al. [12] during the study of the degradation of pure Zn in saline solutions, plasma, and whole blood. Likewise, in all solutions, the Ecorr values of the Zn coating were slightly more noble (higher) than those of the Zn/AgP (0.30 wt.% Agsurf) composite, while the jcorr and CR values of the Zn/AgP (0.30 wt.% Agsurf) composite were lower (approximately half, in the case of PBS and Hank’s solutions) compared to the pure Zn coatings. Therefore, the presence of AgPs in the Zn/AgP coatings decreased their corrosion rate. This result is consistent with that reported by Punith et al. [42], who studied the corrosion of Zn/Ag composites in NaCl saline solutions and associated the lower corrosion rate of Zn/Ag composites with respect to Zn because the Ag particles occluded in the coating minimize defects in the coating, which are active sites for corrosion. However, the trend of our results is contrary to those reported by Sikova-Jasenska et al. [18], who found that by increasing the Ag content in Zn-Ag alloys formed by smelting at 650 °C, the values of jcorr and CR were slightly increased when using Hank’s solution as electrolyte, and those of Törne et al. [17], who reported increases in the corrosion rate of Zn-4Ag alloys (4 wt.% Ag) (formed by smelting at 550 °C) with respect to pure Zn. The observed differences can be explained taking into account that in the Zn-Ag alloy obtained by heat treatment the formation of intermetallic compounds as AgZn3 of low corrosion resistance is favoured, contrary to what happens with Zn/AgP composite electrodeposited coatings in which these types of compounds are not formed.

Table 4.
Corrosion parameters of Zn coatings and Zn/AgP (0.30 wt.% Agsurf) composite coatings in different physiological solutions, obtained from the polarization curves.
On the other hand, the values of jcorr were of the same order of magnitude as those reported for the degradation of Zn-Mg and Zn-Al alloys in Hank’s solution [19], as well as of Zn-Ag alloys in Hank’s solution [18]. Additionally, the values of jcorr obtained for the Zn/AgP composites in the three different electrolytes (PBS, Ringer’s and Hank’s solutions) were lower than those reported for the degradation of Mg in Ringer’s solution (41.7 µA cm−2) [41] or in simulated body fluid (SBF) (53 µA cm−2) [3]. Based on the above results, it is possible to propose Zn/AgP composites as a viable alternative to temporarily protect substrates in physiological environments.
Additionally, Table 4 shows the values of the daily amount of dissolved Zn mass (vdiss) in each of the degradation tests, calculated from the obtained CR values. These values are in the range of 0.1 mg cm−2 day−1 to 0.7 mg cm−2 day−1, values lower than the necessary daily intake of Zn, which is 8–25 mg day−1 for adults and 2 at 8 mg day−1 for children [14,18]. Therefore, from a point of view of biocompatibility, it could be considered that the amount of Zn dissolved under the conditions studied does not present toxicological problems to the organism, provided that the exposed area inside an implant does not lead to concentrations above the permissible range. Additionally, considering the percentage of AgP in the dissolved mass, the amount of Ag mass (approx. 0.24 µg day−1 cm−2) is lower than the recommended daily intake (27 µg day−1) [43], so it does not represent problems of toxicity either.
3.3.2. Immersion Test
In addition to the study of polarization curves, the corrosion resistance of the Zn and Zn/AgP (0.30 wt.% Agsurf) coatings was studied by immersion tests, in accordance with NACE Standard TMO 169/G31-12ª [32]. For this test, coatings of Zn and Zn/AgP (0.30 wt.% Agsurf) were immersed in the three physiological environments considered, while maintaining the temperature at 37 °C. The coatings were removed after different immersion times (7, 22, and 40 days), and their surface was analysed by SEM-EDS to obtain information on the corrosion products.
Figure 7 shows the SEM images obtained from the Zn (Figure 7a) and Zn/AgP (0.30 wt.% Agsurf) coatings (Figure 7b) after immersion for the different times. In each solution, both coatings had a similar superficial appearance. In PBS, after 7 days of immersion, the presence of crystalline structures was observed on the surface of both coatings. The elemental mapping of the surface (Figure S4a, additional information) shows that these crystals are formed of P and O, which cover the surface of Zn, forming a protective film. These results corroborate the formation of a passivating film observed in the polarization curves in PBS. The formation of an insoluble phosphate film can be attributed to the presence of hydrogen phosphate in PBS, which reacts with the dissolved Zn2+ ions during the corrosion process and forms insoluble Zn-phosphate species. Additionally, after 40 days of testing, the surface of the sample was completely covered by the protective film. Importantly, at the end of the test, the formation of precipitate in the solution was not observed.


Figure 7.
SEM images of Zn coatings (a) and Zn/AgP (b) (0.30 wt.% Ag) composite coatings obtained after different immersion times in different physiological solutions at 37 °C.
In Hank’s solution at seven days of immersion, the formation of a film that partially covered the surface of the coatings was observed. Elemental mapping by EDS showed that this film was composed mainly of Zn and O (Figure S4b, additional information). This result was corroborated by XPS analysis (Figure S5, additional information), whose spectrum presented the characteristic behaviour of ZnO [44]. After 40 days of immersion, the film partially covered the surface because partial detachment of the film was observed.
In Ringer’s solution, the coatings showed the formation of a poorly adherent film, and the elemental mapping (Figure S4c, additional information) indicated that this film was primarily formed of Zn and O. Additionally, after 40 h of immersion, the presence of Fe was detected, which is indicative of substrate corrosion.
After 40 days of immersion, the corrosion rate was evaluated using the following equation [26]:
where CR is the corrosion rate (mm yr−1), W is the weight loss (g), A is the area (cm2), t is the exposure time (h) and ρ is the density of the material (g cm3). Table 5 shows the results of the corrosion rates obtained for both coatings in the different environments studied. The results were slightly higher than those obtained by the polarization curve technique. However, they followed the same trend.

Table 5.
Corrosion rate (CR) of Zn coatings and Zn/AgP (0.30 wt.% Agsurf) composite coatings after immersion in different physiological solutions for 40 days at 37 °C.
3.4. Characterization of Corrosion Products
Surface analysis by XRD was performed to identify the corrosion products formed after immersing the coatings for 40 days in the different electrolytes (Figure 8). These results confirmed the formation of zinc oxide (ZnO) on the surface of the Zn and Zn/AgP (0.30 wt.% Agsurf) coatings after being immersed in Hank’s solution for 40 days at 37 °C (Figure 8a). Likewise, the presence of the Fe signal corroborated the corrosion of the substrate. Notably, although the compound NaHPO4 is present in Hank’s solution, the XRD analysis did not detect the formation of insoluble species of zinc phosphate on the coating surfaces, most likely due to the presence of chloride ions in the solution, which inhibits the formation of zinc phosphates and promotes the formation of soluble species.

Figure 8.
Normalized XRD patterns of Zn coatings and Zn/AgP (0.30 wt.% Ag) composite coatings obtained after 40 days of immersion at 37 °C in (a) Hank’s solution, (b) Ringer’s solution and (c) PBS. Zn (JCPDS 04-0831), ZnO (JCPDS 36-1451), Zn3(PO4)2⋅2H2O (JCPDS 041-0493), ZnCO3 (JCPDS 08-0449), Fe (JCPDS 06-0696), KH2(PO4) (JCPDS 01-527).
A similar behaviour was observed in the XRD diffractograms obtained from the Zn and Zn/AgP (0.30 wt.% Agsurf) coatings immersed in Ringer’s solution (Figure 8b). However, in addition to the ZnO and Fe signals, signals associated with ZnCO3 were observed due to the interaction of Zn2+ ions (dissolved during corrosion) and CO32- ions that are present in Ringer’s solution under alkaline conditions.
The XRD diffractograms obtained from the Zn and Zn/AgP (0.30 wt.% Agsurf) coatings immersed for 40 days in PBS at 37 °C (Figure 8c) showed the presence of signals associated with Zn3(PO4)2·2H2O, which in the absence of chloride ions forms a passivating film on the surface of the coatings. Additionally, the formation of KH2PO4 and ZnO was observed.
4. Conclusions
In this study, Zn/AgP composite coatings were formed by electrodeposition. The antibacterial properties of the coatings were evaluated using P. aeruginosa NEJ01R as a model Gram-negative bacteria. Likewise, the degradation rate of these coatings in physiological environments was evaluated by means of polarization curve assessment and immersion tests using PBS, Hank’s and Ringer’s solutions as electrolytes.
Zn/AgP composite coatings with different contents of occluded Ag that was homogenously distributed in the metallic matrix were obtained by varying the concentration of AgPs in the electrolytic solution. The antibacterial capacity of the Zn/AgP composite coatings depended on the Ag content in the coating and on the contact time. Percentages close to 100% inhibition were obtained after 30 min of contact for Zn/AgP composite coatings with AgP content in the range between 0.18 and 0.30 wt.%.
The values of the corrosion current density (jcorr) of the Zn/AgP coatings (0.30 wt.% Agsurf) evaluated in PBS, Hank’s and Ringer’s solutions were 5.18, 17.77 and 10.10 µA cm−2, respectively, which are similar to those normally considered for the design of biodegradable materials, such as Zn-Mg and Zn-Al, and lower than those reported for Mg (~50 µA cm−2). Additionally, the amount of dissolved mass of the Zn/AgP coatings in the physiological environments considered (PBS, Hank’s and Ringer’s solutions) were 0.15, 0.29, and 0.15 mg cm−2 day−1, respectively, which are much lower than the recommended daily Zn intake (15–100 mg day−1).
The XRD analysis confirmed the formation of ZnO species on the surface of the coatings immersed in Ringer’s and Hank’s solutions, while the coatings immersed in PBS showed the formation of an adherent film of Zn3(PO4)2·2H2O. This protective film is formed by the reaction between the Zn2+ ions produced by the dissolution of the Zn film and the PO42- anions present in the solution. This reaction did not occur in coatings immersed in Hank’s solution, which does contain PO42− ions, because it also contains chloride ions that can easily form soluble chloride species.
Based on the results obtained, it is possible to propose Zn/AgP composites coatings as an alternative for use as temporary biodegradable protective coatings of implants with the capacity to inhibit the formation of bacterial biofilms on their surface.
Supplementary Materials
The following are available online at https://www.mdpi.com/2079-6412/10/4/337/s1, Figure S1 SEM images of Zn/AgP composite coatings obtained from S0 solution (=81 g·L−1 ZnCl2 + 25 g·L−1 H3BO3 + 208.8 g·L−1 KCl + 1.5 g·L−1 PEG 8000 + 0.2 g·L−1 BDA + 0.03 g·L−1 cetyl trimethylammonium hydrogen sulphate (CTHS) + 2.8 g·L−1 triethanolamine) + 3.5 g·L−1 AgNPs. Figure S2 Elemental mapping analyses of the Zn/AgP coatings obtained from. (a) S0 solution + 0.5 g·L−1 AgPs (b) S0 solution + 1.5 g·L−1 AgPs. (c) S0 solution + 3.5 g·L−1 AgPs. (d) S0 solution + 4.5 g·L−1 AgPs. Figure S3. GD-OES profiles obtained from Zn/AgP composite coatings formed from. S0 solution with: (a) 1.0 g·L−1 AgPs, (b) 2.5 g·L−1 AgPs and (c) 3.5 g·L−1AgPs by applying 8.5 mA cm−2 for 60 min a 25 °C. Figure S4. (a) Elemental mapping analyses of the Zn and Zn/AgP (0.30 wt.% Ag) coatings obtained after 7 days of immersion in PBS´s solutions at 37 °C. (b) Elemental mapping analyses of the Zn coatings obtained after 7 days of immersion in Hank´s solutions at 37 °C. (c) Elemental mapping analyses of the Zn/AgP (0.30 wt.% Ag) coatings obtained after 7 days of immersion in Ringer´s solutions at 37 °C. Figure S5. XPS analyses of the Zn and Zn/AgP (0.30 wt.% Ag) coatings obtained after 7 days of immersion in Hank´s solutions at 37 °C.
Author Contributions
Methodology, Y.R.-V. and F.J.B.-V.; validation, R.H.L., E.A.-S. and J.V.-A.; formal analysis, J.G.F.; investigation, B.C.-R. and J.M.; writing—original draft preparation, G.T.; writing—review and editing, G.T. and R.O.; project administration, A.T.-L.; funding acquisition, A.T.-L. All authors have read and agreed to the published version of the manuscript.
Funding
This research was funded by Consejo Nacional de Ciencia y Tecnología (CONACyT), México [project CF/2019-6691].
Acknowledgments
Berenice Castro Rodriguez is grateful to CONACyT for scholarship support.
Conflicts of Interest
The authors declare no conflict of interest.
References
- Cheng, J.; Liu, B.; Wu, Y.H.; Zheng, Y.F. Comparative in vitro study on pure metals (Fe, Mn, Mg. Zn and W) as biodegradable metals. J. Mater. Sci. Technol. 2013, 29, 619–627. [Google Scholar] [CrossRef]
- Li, N.; Zheng, Y. Novel Magnesium alloys developed for biomedical applications: A review. J. Mater. Sci. Technol. 2013, 29, 489–502. [Google Scholar] [CrossRef]
- Vojtech, D.; Kubásek, J.; Serák, J.; Novák, P. Mechanical and corrosion properties of newly developed biodegradable Zn-based alloys for bone fixation. Acta Biomater. 2011, 7, 3515–3522. [Google Scholar] [CrossRef] [PubMed]
- Heublein, B.; Rohde, R.; Kaese, V.; Niemeyer, M.; Hartung, W.; Haverich, A. Biocorrosion of magnesium alloys: A new principle in cardiovascular implant technology? Heart 2003, 89, 651–656. [Google Scholar] [CrossRef] [PubMed]
- Krause, A.; Von der Höh, N.; Bormann, D.; Krause, C.; Bach, F.W.; Windhagen, H.; Meyer-Lindenberg, A. Degradation behavior and mechanical properties of magnesium implants in rabbit tibiae. J. Mater. Sci. 2010, 45, 624–632. [Google Scholar] [CrossRef]
- Zhang, S.; Li, J.A.; Song, Y.; Zhao, C.L.; Zhang, X.; Xie, C.; Zhang, Y.; Tao, H.; He, Y.; Jiang, Y.; et al. In vitro degradation, hemolysis and MC3T3-E1 cell adhesion of biodegradable Mg–Zn alloy. Mater. Sci. Eng. C 2009, 29, 1907–1912. [Google Scholar] [CrossRef]
- Sun, Y.; Zhang, B.; Wang, Y.; Geng, L.; Jiao, X. Preparation and characterization of a new biomedical Mg–Zn–Ca alloy. Mater. Des. 2012, 34, 58–64. [Google Scholar] [CrossRef]
- Peuster, M.; Hesse, C.; Schloo, T.; Fink, C.; Beerbaum, P. Long-term biocompatibility of a corrodible peripheral iron stent in the porcine descending aorta. Biomaterials 2006, 27, 4955–4962. [Google Scholar] [CrossRef]
- Peuster, M.; Wohlsein, P.; Brugmann, M.; Ehlerding, M.; Seidler, K.; Fink, C. A novel approach to temporary stenting: Degradable cardiovascular stents produced from corrodible metal—Results 6–18 months after implantation into New Zealand white rabbits. Heart 2001, 86, 563–569. [Google Scholar] [CrossRef]
- Hermawan, H.; Purnama, A.; Dube, D.; Couet, J.; Montovani, D. Fe–Mn alloys for metallic biodegradable stents: Degradation and cell viability studies. Acta Biomater. 2010, 6, 1852–1860. [Google Scholar] [CrossRef]
- Schinhammer, M.; Steiger, P.; Moszner, F.; Löffler, J.F.; Uggowitzer, P.J. Degradation performance of biodegradable Fe-Mn-C (-Pd) alloys. Mater. Sci. Eng. C 2013, 33, 1882–1893. [Google Scholar] [CrossRef] [PubMed]
- Törne, K.; Larsson, M.; Norlin, A.; Weissenrieder, J. Degradation of zinc in saline solutions, plasma, and whole blood. J. Biomed. Mater. Res. Part B 2016, 104, 1141–1151. [Google Scholar] [CrossRef] [PubMed]
- Bowen, P.K.; Drelich, J.; Goldman, J. Zinc exhibits ideal physiological corrosion behavior for bioadsorbables stents. Adv. Mater. 2013, 25, 2577–2582. [Google Scholar] [CrossRef]
- Fosmire, G.J. Zinc toxicity. Am. J. Clin. Nutr. 1990, 51, 225–227. [Google Scholar] [CrossRef] [PubMed]
- Tapiro, H.; Tew, K.D. Trace elements in human physiology and pathology: Zinc and metallothioneins. Biomed. Pharmacother. 2003, 57, 399–411. [Google Scholar] [CrossRef]
- Niu, J.; Tang, Z.; Huang, H.; Pei, H.J.; Zhang, H.; Yuan, G.; Ding, W. Research on a Zn-Cu alloy as a biodegradable material for potential vascular stents applications. Mater. Sci. Eng. C 2016, 69, 407–413. [Google Scholar] [CrossRef]
- Törne, K.B.; Khan, F.A.; Örberg, A.; Weissenrieder, J. Zn-Mg and Zn-Ag degradation mechanism under biologically relevante conditions. Surf. Innov. 2018, 6, 81–82. [Google Scholar] [CrossRef]
- Sikora-Jasinska, M.; Mostaed, E.; Mostaed, A.; Beanland, R.; Mantovani, D.; Vedani, M. Fabrication, mechanical properties and in vitro degradation behavior of newly developed Zn-Ag alloys for degradable implants applications. Mater. Sci. Eng. C 2017, 77, 1170–1181. [Google Scholar] [CrossRef]
- Mostaed, E.; Sikora-Jasinska, M.; Mostaed, A.; Loffredo, S.; Demir, A.G.; Previtali, B.; Mantovani, D.; Beuland, R.; Vedani, M. Novel Zn-based alloys for biodegradable stent applications: Design, development and in vitro degradation. J. Mech. Behav. Biomed. Mater. 2016, 60, 581–602. [Google Scholar] [CrossRef]
- Hehrlein, C.; Schorch, B.; Kress, N.; Arab, A.; Von zur Mühlen, C.; Bode, C. Zn-alloy provides a novel platform for mechanically stable bioresorbable vascular stents. PLoS ONE. 2019, 14, e0209111. [Google Scholar] [CrossRef]
- Alabbasi, A.; Liyanaarachchi, S.; Kannan, M.B. Polylactic acid coating on a biode-gradable magnesium alloy: An in vitro degradation study by electrochemical impedance spectroscopy. Thin Solid Films 2012, 520, 6841–6844. [Google Scholar] [CrossRef]
- Park, M.; Eun, J.; Chun, L.; Park, G.; Ho, S.; Hyun, L.; Seok, K.; Bin Choy, Y. Polycaprolactone coating with varying thicknesses for controlled corrosion of magnesium. J. Coat. Technol. Res. 2013, 10, 695–706. [Google Scholar] [CrossRef]
- Ascencio, M.; Pekguleryuz, M.; Omanovic, S. Corrosion behaviour of polypyrrole-coated WE43 Mg alloy in a modified simulated body fluid solution. Corr. Sci. 2018, 133, 261–275. [Google Scholar] [CrossRef]
- Chang, L.; Tian, L.; Liu, W.; Duan, X. Formation of dicalcium phosphate dihydrate on magnesium alloy by micro-arc oxidation coupled with hydrothermal treatment. Corr. Sci. 2013, 72, 118–124. [Google Scholar] [CrossRef]
- da Conceição, T.F.; Scharnagl, N.; Dietzel, W.; Kainer, K.U. Controlled degradation of a magnesium alloy in simulated body fluid using hydrofluoric acid treatment followed by polyacrylonitrile coating. Corr. Sci. 2012, 62, 83–89. [Google Scholar] [CrossRef]
- Rasouli, M.R.; Restrepo, C.; Maltenfort, M.; Purtill, J.J.; Parvizi, J. Risk factors for surgical site infection following total joint arthroplasty. J. Bone Jt. Surg. Am. 2014, 96, e158. [Google Scholar] [CrossRef]
- Hernández, A.; Yagüe, G.; Vázquez, E.G.; Simón, M.; Parrado, L.M.; Canteras, M.; Gómez, J. Infecciones nosocomiales por Pseudomonas aeruginosa multiresistente incluido carbapenémicos: Factores predictivos y pronósticos. Estudio prospectivo 2016–2017. Rev. Esp. Quimioter. 2018, 31, 123–130. [Google Scholar]
- Fazzeli, H.; Akbari, R.; Moghim, S.; Narimani, T.; Arabestani, M.R.; Ghoddousi, A.R. Pseudomonas aeruginosa infections in patients, hospital means, and personnel’s specimens. J. Res. Med. Sci. 2012, 17, 332–337. [Google Scholar]
- ISO 22196. Measurement of antibacterial activity on plastics and other non-porous surfaces. In International Organization for Standardization; ISO: Geneva, Switzerland, 2011. [Google Scholar]
- ASTM E2149-13a. Standard Test Method for Determining the Antimicrobial Activity of Antimicrobial Agents Under Dynamic Contact Conditions. In American Society for Testing and Materials; ASTM: West Conshohocken, PA, USA, 2013. [Google Scholar]
- ASTM G59-97. Standard Test Method for Conducting Potentiodynamic Polarization Resistance Measurements. In American Society for Testing and Materials; ASTM: West Conshohocken, PA, USA, 2014. [Google Scholar]
- NACE TMO169/G31-12a. Standard Guide for laboratory Immersion corrosion testing of metals; NACE: Houston, TE, USA, 2012. [Google Scholar]
- Trejo, G.; Ortega, R.; Meas, Y. The effect of polyethylene glicol 8000 additive on the deposition mechanism and morphology of Zn deposits. Plat. Surf. Finish. 2002, 89, 84–87. [Google Scholar]
- Kazimierczak, H.; Morgiel, J.; Swiatek, Z.; Vega, J.M. Effect of Mo addition on corrosion of Zn coatings electrodeposited on Steel. Corr. Sci. 2018, 135, 107–119. [Google Scholar] [CrossRef]
- Kazimierczak, H.; Szymkiewics, K.; Gileadi, E.; Eliaz, N. The effect of direct and pulsed current in the presence of surfactants on the electrodeposition of Zn-SiC nanocomposite coatings. Coatings 2019, 9, 93. [Google Scholar] [CrossRef]
- Méndez-Albores, A.; González-Arellano, S.G.; Reyes-Vidal, Y.; Torres, J.; Ţălu, Ş.; Cercado, B.; Trejo, G. Electrodeposited chrome/silver nanoparticle (Cr/AgNPs) composite coatings: Characterization and antibacterial activity. J. Alloy. Compd. 2017, 710, 302–311. [Google Scholar] [CrossRef]
- Masaadeh, H.A.; Jaran, A.S. Incident of Pseudomonas aeruginosa in post-operative wound infection. Am. J. Infect. Dis. 2009, 5, 1–6. [Google Scholar] [CrossRef]
- Ohlin, A.; Mattsson, E.; Mörgelin, M.; Davies, J.R.; Esvensâter, G.; Corvec, S.; Tengvall, P.; Riesbeck, K. Titanium granules pre-treated with hydrogen peroxide inhibit growth of bacteria associated with post-operative infections in spine surgery. Eur. Spine J. 2018, 27, 2463–2468. [Google Scholar] [CrossRef] [PubMed]
- Bundy, K.J.; Butler, M.F.; Hochman, R.F. An investigation of the bacteriostatic properties of pure metals. J. Biomed. Mater. Res. 1980, 14, 653–663. [Google Scholar] [CrossRef] [PubMed]
- Li, H.F.; Xi, H.; Zheng, Y.F.; Cong, Y.; Zhou, F.Y.; Qiu, K.J.; Wang, X.; Chen, S.H.; Huang, L.; Tian, L.; et al. Development of Biodregradable Zn-1X binary alloys with nutrient alloying elements Mg, Ca and Sr. Sci. Rep. 2015, 5, 10719. [Google Scholar] [CrossRef]
- Jamesh, M.; Kumar, S.; Sankara Narayanan, T.S.N. Corrosion behavior of commercially pure Mg and ZM21 Mg alloy in Ringer’s solution-Long term evaluation by EIS. Corr. Sci. 2011, 53, 645–654. [Google Scholar] [CrossRef]
- Punith Kumar, M.K.; Srivastava, C. Morphological and electrochemical characterization of electrodeposited Zn-Ag nanoparticle composite coatings. Mater. Charact. 2013, 85, 82–91. [Google Scholar] [CrossRef]
- Hadrup, N.; Lam, H.R. Oral toxicity of silver ions, silver nanoparticles and coloidal silver, a rewiew. Regul. Toxicol. Pharmacol. 2014, 68, 1–7. [Google Scholar] [CrossRef]
- Al-Gaashani, R.; Radiman, S.; Daud, A.R.; Tabet, N.; Al-Douri, Y. XPS and optical studies of different morphologies of ZnO nanostructures prepared by microwave methods. Ceram. Int. 2013, 39, 2283–2292. [Google Scholar] [CrossRef]
© 2020 by the authors. Licensee MDPI, Basel, Switzerland. This article is an open access article distributed under the terms and conditions of the Creative Commons Attribution (CC BY) license (http://creativecommons.org/licenses/by/4.0/).